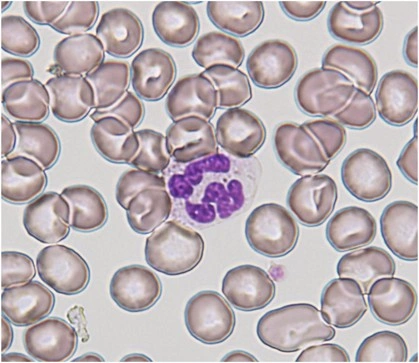

PNPLA6 유전자, 중성지방 대사와 신경퇴행성 질환의 연관성
2024년 5월 15일, 미국 국립보건원(NIH) 연구진은 PNPLA6 유전자와 관련된 신경퇴행성 질환의 중요한 원인을 밝혀냈습니다. 이 연구는 PNPLA6 유전자가 인간의 염색체 19에 위치하며, 신경퇴행성 대상 에스테라아제(NTE)라는 효소를 코딩한다는 사실에 대한 깊은 이해를 제공하며, 유전자 변이가 신경세포의 기능과 생존에 미치는 영향을 규명했습니다.
PNPLA6 유전자 돌연변이, 신경세포 손상과 신경퇴행성 질환의 관계
연구진은 PNPLA6 유전자의 돌연변이가 신경퇴행성 질환을 유발하는 메커니즘을 밝히며, 향후 맞춤형 진단과 치료 개발에 중요한 기초를 마련했습니다. 이 획기적인 연구는 PNPLA6 변이가 신경세포의 중성지방 대사와 세포막 안정성에 영향을 미쳐 다양한 신경퇴행성 질환을 유발할 수 있음을 보여주며, 신경퇴행성 질환의 심각도와 관련된 중요한 단서를 제시합니다.
신경퇴행성 질환의 PNPLA6 유전자
"PNPLA6 유전자는 인간의 염색체 19에 위치한 유전자로, 주로 신경퇴행성 대상 에스테라아제(neurodegenerative target esterase, NTE)로 알려진 효소를 코딩합니다. "
NIH 연구진은 PNPLA6 유전자와 관련된 신경퇴행성 질환의 복잡한 분자 메커니즘을 규명하여,임상, 유전 및 분자 수준에서 더 깊이 이해할 수 있는 길을 열었습니다. 이는 맞춤형 진단 및 치료 접근법 개발에 중요한 단서를 제공합니다.
PNPLA6 관련 질환은 신경세포 내 지질 대사와 막 안정성을 조절하는 효소인 신경퇴행성 대상 에스테라아제(특정 유기물을 분해하는 효소)(NTE)의 기능을 저해하는 돌연변이로 인해 발생합니다. NTE 활동의 억제는 유전성 경직성 다리마비,올리버-맥파레인 증후군 및 유기인산염 유발 지연 신경병증과 같은 여러 신경학적 질환과 관련이 있습니다.
PNPLA6 유전자는 중성지방의 대사를 조절하는 중요한 유전자로 알려져 있다. 중성지방은 에너지 저장 및 공급에 중요한 역할을 하는 지방의 한 유형이다. PNPLA6 유전자의 변이는 중성지방의 적절한 대사에 영향을 미치는데, 이로 인해 다양한 신경퇴행성 질환의 발병 가능성이 증가할 수 있다.
또한, PNPLA6 유전자의 변이는 신경세포의 기능과 생존에도 영향을 미칠 수 있다. 이 유전자는 신경세포 내의 중성지방 녹이와 세포막의 구조를 유지하는 데 중요한 역할을 한다. 그러므로 PNPLA6 유전자의 변이는 중성지방 녹이의 이상으로 인해 신경세포에 손상을 초래하여 신경퇴행성 질환의 발병을 촉진할 수 있다.
연구 결과, 질병 증상의 심각성은 DNA 코드 구성 요소인 뉴클레오타이드(아데닌(A), 티민(T), 시토신(C), 구아닌(G))의 단일 치환에 따라 결정됩니다. 돌연변이가 PNPLA6 유전자 내에서 발생하는 위치에 따라 NTE 기능에 미치는 영향이 달라집니다. 연구자들은 환자들에게서 발견된 돌연변이와 동일한 변이를 가진 쥐 모델을 개발하여 PNPLA6 변이를 질병 심각도에 따라 분류하는 실험을 진행했습니다. 이를 통해 NTE 활동과 PNPLA6 관련 증상의 심각성 사이의 상관관계를 관찰할 수 있었습니다.
뉴클레오타이드(nucleotide)는 DNA와 RNA를 구성하는 기본 단위입니다. 뉴클레오타이드는 세 부분으로 구성됩니다: 질소염기, 오탄당(5탄당) 당 분자, 그리고 하나 이상의 인산 그룹입니다.
이 연구는 PNPLA6 유전자 변이에 의한 신경퇴행성 질환의 이해와 치료에 중요한 기여를 하며, 향후 맞춤형 의학 발전에 큰 도움을 줄 것으로 기대됩니다.
'시사' 카테고리의 다른 글
| 냉장고 사용 팁과 올바른 보관으로 신선한 식품 유지하기 (0) | 2024.11.17 |
|---|---|
| 샤오펑의 플라잉카와 자율주행 기술, 전 세계 전기차 시장 (0) | 2024.11.13 |
| 간단한 텍스트 처리 도구로 문자열 제거하고 결과 출력하기 (0) | 2024.11.10 |
| [ 손목닥터 9988 ] 서울시민 건강관리 서비스 운동하고 포인트 얻기 (4) | 2024.10.24 |
| 공기업과 서울 공공기관 이사회 역할과 구성및 서울 주요 공공기관 (5) | 2024.10.24 |